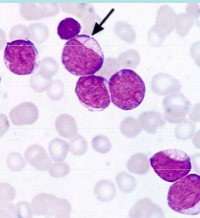

Which medication is associated with hypertrichosis and gum hyperplasia?
A. Azathioprine.
B. Cyclosporin.
C. Methotrexate.
D. Mycophenolate.
E. Tacrolimus.
B. Cyclosporin. Causes hypertrichosis and gum hyperplasia in 5-19%
All other medications cause alopecia.
What is the single most common malignancy of childhood?
What is this a picture of?

Immature lymphocytes.
Note no granules in cytoplasm.
What is pathogenesis of ALL?
Aetiology is unclear but must have
Maturation arrest and
uncontrolled proliferation
What is peak age for ALL?
3 years then steadily decreases with another much smaller peak at approx 16 years.
What is second most common leukaemia of childhood?
AML
What is cure rate of AML?
60-65%
What is treatment of AML?
Cytarabine base chemo for 6-9 months
What are some presenting features of AML?
What is this and what does diagnosis do you consider?
Auer Rod = AML (pathognomonic)
In the FAB classification of AML, M7 is megakaryoblastic leukaemia. What population of people are more likely to have this diagnosis?
Downs Syndrome
In the FAB classification of AML, M3 is APML (Acute Promyelocytic Leukaemia).
What do you need to be careful to look for on diagnosis of APML?
DIC.
Need full coag profile plus fibrinogen and then serial measurements.
What is treatment of APML?
Anthracycline & ATRC - Al Trans Retinoic Acid
Anthracycline and ATRA are used in treatment of APML. What does these drugs do, what is a significant side effect and what is survival?
Anthracycline helps mature blasts into healthier cells.
Beware ATRA syndrome - acute resp failure with pulmonary oedema.
Good outcomes if survive induction.
What are prognostic features of AML?
When is Hodgkins Lymphoma more common?
2nd decade
What is usual presentation of Hodgkins Lymphoma?
Slowly progressing lymphadenopathy - often in teenage girl.
Mediastinal mass
“B” symptoms
Paraneoplastic syndromes ie itch.
Prognosis of Hodgkin Lymphoma?
Good. 80% at 5 years depending on B symptoms.
5 lines on Burkitts Lymphoma
Tumour Lysis Syndrome
Lysis of tumour cells leads to release of intracellular electrolytes incl K+, Ca2+, phosphate and uric acid.
What usually causes fatality in tumour lysis syndrome?
Hyperkalaemia
Why does renal impairment/failure occur in tumour lysis syndrome?
Precipitation of calcium phosphate and uric acid in the tubules.
Calcium phosphate most likely to precipitate but most damage done by uric acid crystals.
What is management of tumour lysis syndrome?
Why should you avoid giving Allopurinol and rasburicase together in treatment of tumour lysis sydrome?
Allopurinol - prevents formation of uric acid
Rasburicase - breaks down uric acid
allopurinol with decrease substrate for rasburicase so waste of medication.